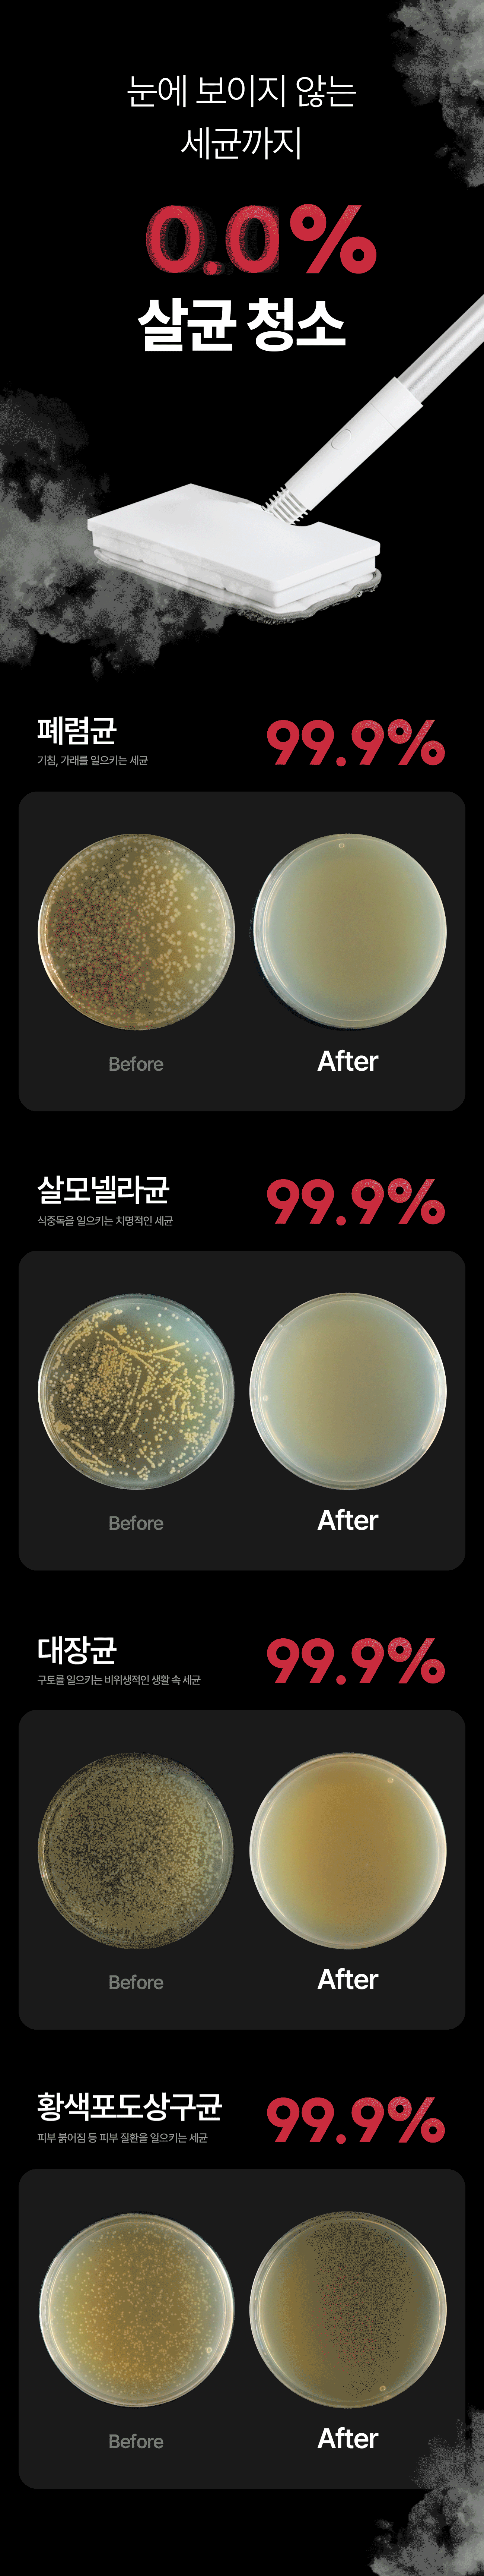

统计时间点:2025年7月4日(星期五)
统计渠道:Wadiz







































































各位支持者大家好,我们是致力于从必需的小价值中不断思考并提出更好生活方式建议的品牌Huvic。此次全新推出的Huvic蒸汽清洁机,利用高温蒸汽可高效清洁地板、厨房、浴室等多种空间,无需化学清洁剂也能实现卫生清洁。
此外,为了提升用户满意度,我们在Wadiz独家以超值优惠提供多种便捷配件喷嘴和支架配置,敬请大家多多支持与关注。
为了让每个人随时随地都能安全便捷地使用,我们严格验证产品的质量与安全性,与支持者沟通协作,共同成长为让日常生活更安心的品牌Huvic。谢谢大家。
Wadiz众筹理由 &
众筹资金使用计划
我们希望通过这次项目,让最真诚关注我们故事和产品、积极沟通的支持者们给予验证和反馈,同时也想让更多人了解Huvic这个品牌。所有支持者信任支持的众筹资金将用于产品的售后管理、改进及开发费用,我们也会继续努力,带来更好的产品回馈大家。
huaco Co.,Ltd